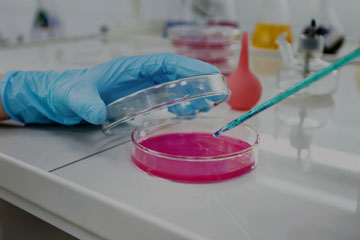
DS Journal of Microbiology

Welcome To DISSCI Publisher
DISSCI is a growing Open Access Publisher with diverse peer reviewed journals supported by Academic Editors, Scholars, Physicians, Instructors, Institutions and Universities covering all the disciplines of the scientific field. We are devoted to advancing open science, excellence in Clinical, Health Care and Physical Science Engineering sectors.
- DISSCI is committed for progressing research, continuous innovation which can accomplish the needs of our communities.
- DISSCI focus on publishing impactful research and allowing robust research practices